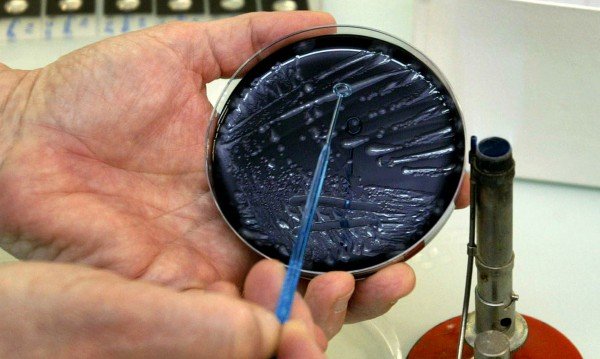
В Пазарджик лекуват първи случай на Легионерска болест

ПИК с нов канал в Телеграм
Последвайте ни в Google News Showcase
Пациент с доказана Легионерска болест се лекува в Инфекциозно отделение на МБАЛ-Пазарджик.
Това е първият случай за областта през тази година, а през миналата са били четири, съобщиха от лечебното заведение. 62-годишният мъж постъпва с висока температура - до 40℃, отпадналост и диария. При обективния преглед се установява и пневмония.
При болния е отхвърлена диагнозата COVID-19 със съвременните методи за диагностика - PCR. Диагнозата Легионерска болест е потвърдена в Националния център по заразни и паразитни болести в София.
Легионерската болест е остро инфекциозно заболяване, характеризиращо се с токси-инфекциозен синдром и тежка пневмония, с възможно развитие на дихателна недостатъчност и остър респираторен дистрес синдром. Причинява се от бактерии от род Legionella.
Легионелите са широко разпространени в природните водоизточници, където паразитират в свободно живеещи амеби. Те имат висока адаптивна способност и лесно колонизират изкуствени водни системи.
Механизмът на предаване на инфекцията е аерогенен, чрез вдишване на воден аерозол, съдържащ легионели. Етиологична диагноза е трудна само по клинични белези, затова се използват и други методи. Най-бърз и достъпен метод е изследването на урина за доказване на антиген.
Заболяването все още се подценява у нас и част от случаите остават неоткрити, коментира началникът на Инфекциозно отделение д-р Мария Пишмишева, цитирана от Дарик.